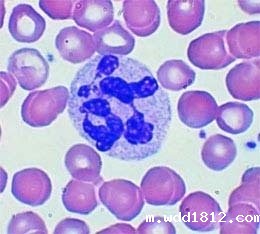
白细胞低的危害

免费咨询热线
13616379298
白细胞也叫白血球,是血液细胞中的重要组成部分。血液分析仪厂家国康生物主产的血液分析仪可快速准确检测出人体的白细胞含量,相关专家告诉您白细胞含量对人体的影响。
白细胞根据有无特殊颗粒分为有粒白细胞和无粒白细胞,根据特殊颗粒的染色特性又分为中性粒细胞、嗜碱性粒细胞和嗜酸性粒细胞。白细胞因是人体免疫系统的第一道防线也 被称为免疫细胞。显微镜的白细胞在血细胞中体积偏大、数量比较少。白细胞的主要作用是吞噬细菌、防御疾病。
白细胞数量高于正常值:
白细胞数量高不是一件好事情,反正是人身体有炎症的表现。若有病菌侵害人体时,包细胞便会穿过毛细血管壁,集中到病菌入侵部位,继而包围并吞噬侵害人体的病菌。
白细胞的数量低于正常值:
人体白细胞计数持续下降会出现头晕、乏力,肢体酸软,食欲减退,精神萎靡、低热等现象。
白细胞减少的原因有使用抗癌药、氯霉素、磺胺类消炎药止痛片、治疗甲亢、糖尿病等药物引起;患上病毒感染、支原体肺炎、传染性肺炎、粟粒性肺结核等感染性疾病和一些血液病会引起白细胞减少;家族遗传也会引起白细胞减少。
药物影响等轻度的白细胞减低是一些生理情况,无需太担心。对于病理性的明显下降应该及时去正规医院接受治疗。避免白细胞持续减少,患上白细胞减少症。
白细胞的增多和减少对人体的危害都是非常大的,血液分析仪厂家国康生物提醒广大朋友定期进行血液分析检测,关爱人体健康。
hth体育中国官网 备案号:鲁ICP备16021555号-7

鲁公网安备 37040302000185号